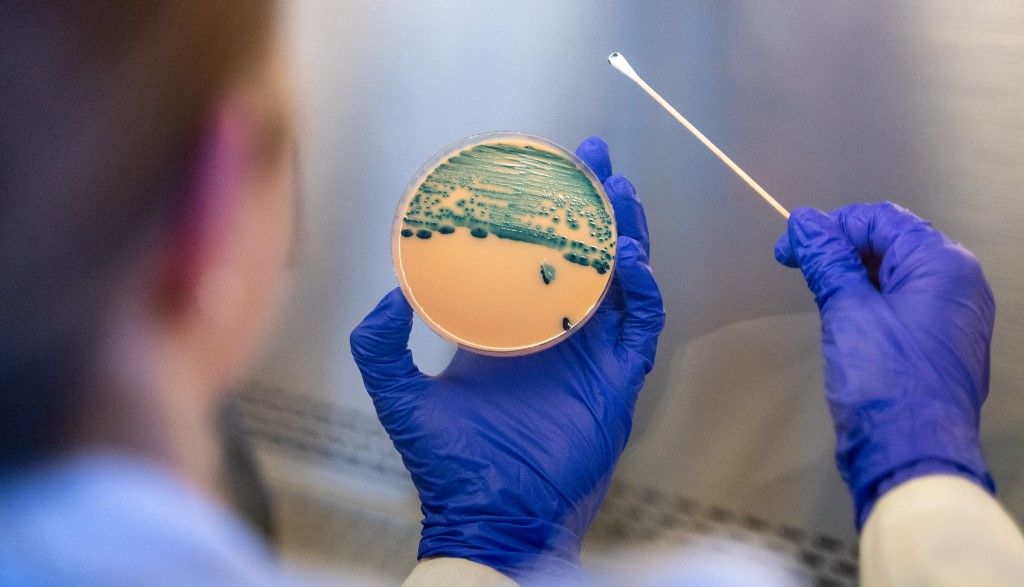
baktérium

Az amerikai Betegségmegelőzési és Járványvédelmi Központok (CDC) friss jelentése szerint a Shigella nevű baktérium olyan változatai jelentek meg, amelyek a leggyakrabban alkalmazott antibiotikumokra sem reagálnak, írja a Fox News.


Az amerikai Betegségmegelőzési és Járványvédelmi Központok (CDC) friss jelentése szerint a Shigella nevű baktérium olyan változatai jelentek meg, amelyek a leggyakrabban alkalmazott antibiotikumokra sem reagálnak, írja a Fox News.
A fertőzés súlyos, sok esetben véres hasmenéssel, lázzal és erős hasi fájdalommal jár.
A kutatók több mint 16 ezer Shigella-mintát elemeztek, antibiotikum-rezisztenciát tesztelve, hogy megállapítsák, hány esetben nem reagálnak a gyakran használt antibiotikumokra.
A vizsgálatok több mint 16 ezer mintát elemeztek, és megdöbbentő eredményre jutottak: míg 2011-ben még egyetlen súlyosan gyógyszer rezisztens esetet sem regisztráltak, addig 2023-ra már a fertőzések mintegy 8,5 százaléka ebbe a kategóriába tartozott.
A baktérium ellenáll az olyan széles körben használt antibiotikumoknak, mint az ampicillin, az azitromicin vagy a ciprofloxacin. A hatóságok szerint jelenleg nincs olyan szájon át szedhető, engedélyezett gyógyszer, amely hatékonyan kezelné ezeket az eseteket.
A fertőzöttek jelentős része súlyos állapotba kerül: minden harmadik beteg kórházi ellátásra szorul. A betegség általában öt-hét napig tart, de egyes esetekben hetekig is elhúzódhat.
Ritkán, de súlyos szövődmények is kialakulhatnak, például véráramfertőzés, idegrendszeri problémák vagy akár veseelégtelenséghez vezető állapotok.

A fertőzések többsége nem külföldről származik: az érintettek több mint nyolcvan százaléka nem utazott az elmúlt időszakban, ami arra utal, hogy a baktérium az Egyesült Államokon belül terjed. A leginkább veszélyeztetett csoportok közé tartoznak a kisgyermekek, az utazók, valamint a legyengült immunrendszerű emberek.
A Shigella rendkívül fertőző: már minimális higiéniai hiányosság is elegendő a terjedéséhez. A baktérium leggyakrabban szennyezett kézen, élelmiszeren vagy felületeken keresztül jut a szervezetbe, de fertőzött víz is okozhat megbetegedést. A szakértők szerint a védekezés alapja a megfelelő higiénia: a rendszeres és alapos kézmosás, a szennyezett víz elkerülése, valamint az élelmiszer-biztonsági szabályok betartása. A hatóságok hangsúlyozzák: aki tüneteket észlel, maradjon otthon, és mielőbb forduljon orvoshoz.
Borítókép: A Shigella baktérium illusztrációja, amely a shigellózisért, a bakteriális hasmenés egy súlyos formájáért felelős (Fotó: Science Photo Library/AFP)
Összesen 0 komment
A kommentek nem szerkesztett tartalmak, tartalmuk a szerzőjük álláspontját tükrözi. Mielőtt hozzászólna, kérjük, olvassa el a kommentszabályzatot.
Portfóliónk minőségi tartalmat jelent minden olvasó számára. Egyedülálló elérést, országos lefedettséget és változatos megjelenési lehetőséget biztosít. Folyamatosan keressük az új irányokat és fejlődési lehetőségeket. Ez jövőnk záloga.
Szóljon hozzá!
Jelenleg csak a hozzászólások egy kis részét látja. Hozzászóláshoz és a további kommentek megtekintéséhez lépjen be, vagy regisztráljon!